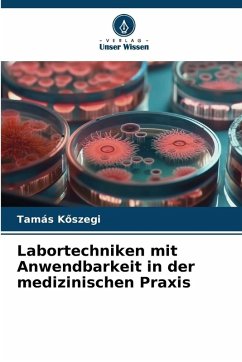

Suchergebnisse für "OmniScriptum"
5000 Artikel gefunden
1 Aktuelle Seite 2 Zur Seite 2 3 Zur Seite 3 4 Zur Seite 4 5 Zur Seite 5 6 Zur Seite 6...Weitere Seiten99+Zur letzten Seite, Seite 100Zur nächsten SeiteZur letzten Seite
1 Aktuelle Seite 2 Zur Seite 2...Weitere Seiten99+Zur letzten Seite, Seite 100Zur nächsten SeiteZur letzten Seite
Ähnlichkeitssuche: Fact®Finder von OMIKRON